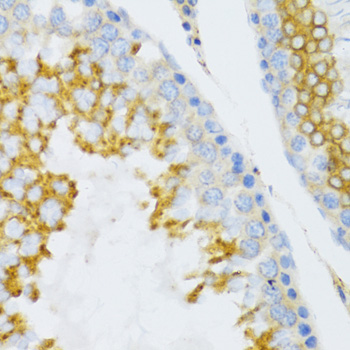
Immunohistochemistry - PTN Polyclonal Antibody

-
Product Name
PTN Polyclonal Antibody
- Documents
-
Description
Polyclonal antibody to PTN
-
Tested applications
WB, IHC
-
Species reactivity
Human, Mouse
-
Alternative names
PTN antibody; HARP antibody; HB-GAM antibody; HBBM antibody; HBGF-8 antibody; HBGF8 antibody; HBNF antibody; HBNF-1 antibody; NEGF1 antibody; OSF-1 antibody; pleiotrophin antibody
-
Isotype
Rabbit IgG
-
Preparation
Antigen: A synthetic Peptide of human PTN
-
Clonality
Polyclonal
-
Formulation
PBS with 0.02% sodium azide, 50% glycerol, pH7.3.
-
Storage instructions
Store at -20℃. Avoid freeze / thaw cycles.
-
Applications
WB 1:500 - 1:2000
IHC 1:50 - 1:200 -
Validations

Western blot - PTN Polyclonal Antibody
Western blot analysis of extracts of various cell lines, using PTN antibody at 1:400 dilution._Secondary antibody: HRP Goat Anti-Rabbit IgG (H+L) at 1:10000 dilution._Lysates/proteins: 25ug per lane._Blocking buffer: 3% nonfat dry milk in TBST._Detection: ECL Enhanced Kit ._Exposure time: 60s.
Immunohistochemistry - PTN Polyclonal Antibody
Immunohistochemistry of paraffin-embedded mouse testis using PTN Antibody at dilution of 1:100 (40x lens).
-
Background
Secreted growth factor that induces neurite outgrowth and which is mitogenic for fibroblasts, epithelial, and endothelial cells. Binds anaplastic lymphoma kinase (ALK) which induces MAPK pathway activation, an important step in the anti-apoptotic signaling of PTN and regulation of cell proliferation. Binds to cell-surface target proteins via their chondroitin sulfate groups. Down-regulates PTPRZ1 activity.
Related Products / Services
Please note: All products are "FOR RESEARCH USE ONLY AND ARE NOT INTENDED FOR DIAGNOSTIC OR THERAPEUTIC USE"
